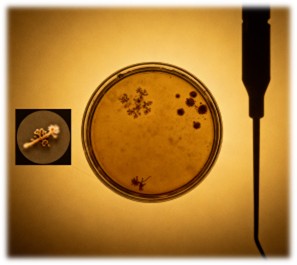

- Home
- Resource
- Explore & Learn
- Novel PCR Assay for Invasive Aspergillosis Diagnosis and Azole-Resistance Detection
- Home
- IVD
- By Technology Types
- By Diseases Types
- By Product Types
- Research
- Resource
- Distributors
- Company
Aspergillosis, a spectrum of diseases caused by fungi within the genus Aspergillus, poses a significant health threat worldwide, particularly to immunocompromised individuals. The most pathogenic species, Aspergillus fumigatus, is responsible for a range of clinical manifestations, from allergic reactions to life-threatening invasive infections. Invasive aspergillosis (IA) is a severe condition with high mortality rates, especially in patients with hematological malignancies, organ transplant recipients, and those on prolonged corticosteroid therapy. Early and accurate diagnosis is crucial for initiating appropriate antifungal therapy and improving patient outcomes.
Fig.1 Analytical performance of the MycoGENIE real-time PCR. The efficiency and dynamic range of the PCR are shown. (Dannaou E., et al., 2017)
Diagnosing aspergillosis remains challenging due to the non-specific nature of clinical symptoms and radiological findings. Patients with IA often present with fever, cough, dyspnea, and chest pain, symptoms that overlap with various other pulmonary infections. Radiological imaging, such as computed tomography (CT), may reveal nodules, cavities, or ground-glass opacities, but these findings are not pathognomonic for aspergillosis. Consequently, reliance on clinical and radiological criteria alone can lead to misdiagnosis and delayed treatment.
Traditional diagnostic methods for aspergillosis include direct microscopy, culture, and histopathological examination. While these techniques are valuable, they suffer from several limitations. Direct microscopy has low sensitivity, especially in non-invasive samples. Culture, although specific, is time-consuming and may yield false-negative results due to prior antifungal therapy or fastidious growth requirements. Histopathological examination requires invasive procedures, such as lung biopsy, which may not be feasible in critically ill patients.
The limitations of conventional diagnostic methods have necessitated the development of more sensitive and rapid techniques. Molecular diagnostics, particularly polymerase chain reaction (PCR)-based assays, have emerged as a promising alternative. PCR allows for the amplification and detection of specific fungal DNA sequences, enabling early and accurate diagnosis of aspergillosis.
Among the various PCR-based assays available, the MycoGENIE A. fumigatus real-time PCR kit stands out as a novel and commercially viable option. This multiplex assay is designed to detect DNA from the A. fumigatus species complex by targeting the multicopy 28S rRNA gene. Additionally, it identifies specific mutations (TR34 and L98H) in the single-copy-number cyp51A gene, which are associated with azole resistance—a growing concern in the management of aspergillosis.

The MycoGENIE kit has demonstrated high analytical sensitivity and specificity. In a study evaluating its performance, the limit of detection (LoD) for the Aspergillus 28S rRNA gene was found to be less than one copy, while the LoD for the cyp51A gene harboring the TR34 and L98H mutations was six copies. No cross-reactivity was detected with various other fungi and bacteria, indicating excellent specificity.

Clinical validation of the MycoGENIE kit involved testing respiratory and serum samples from patients with proven or probable aspergillosis. Among respiratory samples, the sensitivity and specificity were 92.9% and 90.1%, respectively. For serum samples, the sensitivity reached 100%, with a specificity of 84.6%. These results underscore the kit's potential for accurate diagnosis in both sample types.

The performance of the MycoGENIE kit is comparable to that of other commercially available PCR assays, such as the AsperGenius kit. Both kits combine the detection of Aspergillus DNA with the identification of cyp51A mutations associated with azole resistance. However, the MycoGENIE kit's optimized DNA extraction protocol and efficient magnetic particle-based extraction method contribute to its high sensitivity, particularly in serum samples.
If you have related needs, please feel free to contact us for more information or product support.
Reference
We provide molecular diagnostic kits, which are efficient tools designed for molecular biology research and clinical diagnosis and can accurately detect changes in nucleic acid (DNA/RNA) sequences, structures, or expression levels in biological samples, which help medical research such as disease diagnosis, pathogen detection, and genetic disease screening. Specifically covering the following types:
This article is for research use only. Do not use in any diagnostic or therapeutic application.
|
There is no product in your cart. |